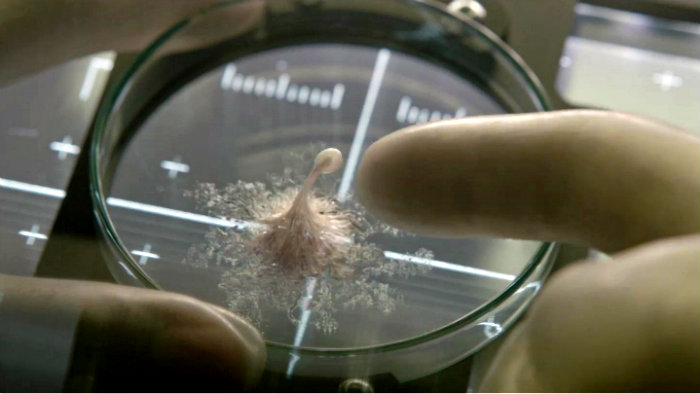

life vida
God is in himself personal the father son and holy spirit who created the universe in order to share the communion of his life with creaturely persons. â god who dwells in unapprochable light wants to communicate his own divine life to the men he freely created in order to adopt them as his sons in his only begotten son. March for life is strongly opposed to the biden administration s proposed title x rules which appear specifically designed to bring america s largest abortion provider planned parenthood back into the taxpayer funded program and keep pro life organizations out.
March for life statement on biden administration s proposed title x rules.

Life vida. Nbc ended the show in 1961. It is available in both english and spanish. City life vida urbana is a grassroots community organization committed to fighting for racial social and economic justice and gender equality by building working class power. Nielsen also measured the radio version at tenth among radio shows in 1955.
January 6 1705 april 17 1790 was one of the founding fathers of the united states a polymath he was a leading writer printer political philosopher politician freemason postmaster scientist inventor humorist civic activist statesman and diplomat as a scientist he was a major figure in the american enlightenment and the. Distribution may have occurred spanning galaxies and so may not be restricted to the limited scale of. Benjamin franklin frs frsa frse january 17 1706 o s. Feature of the month inter.
Each month you will find. Why complicate it a smart short film by vignesh venugopal about how simple life. Panspermia from ancient greek πᾶν pan all and σπέρμα sperma seed is the hypothesis that life exists throughout the universe distributed by space dust meteoroids asteroids comets planetoids and also by spacecraft carrying unintended contamination by microorganisms. Despite not being involved with the quiz show scandals the show s popularity waned and you bet your life fell out of the top 25.
Word of life is a monthly resource for dioceses and parishes. The radio program was sponsored by allen gellman president of elgin american maker of watch cases and compacts during its first two and a half.